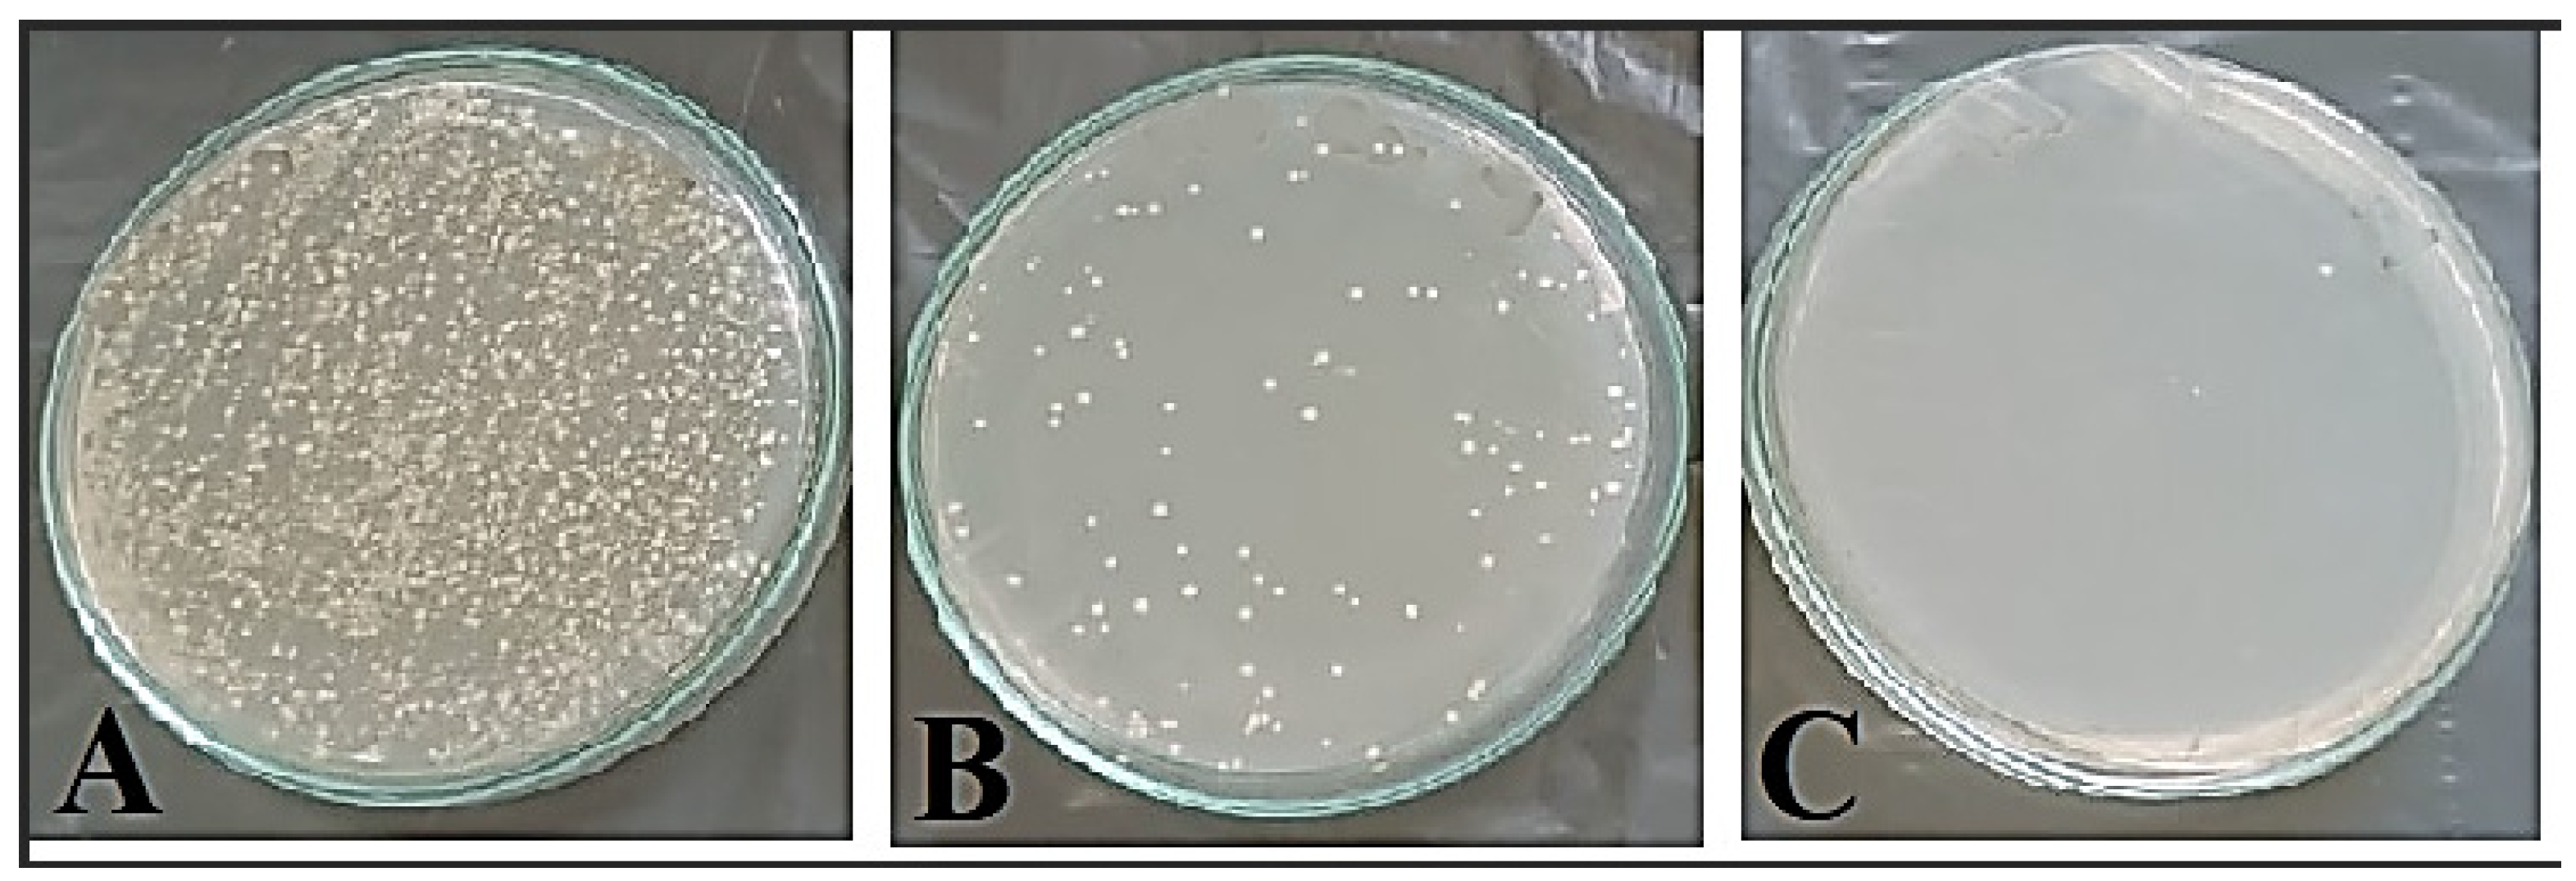
Microorganisms 11 02341 g007

Myco-Synthesized Selenium Nanoparticles as Wound Healing and Antibacterial Agent: An In Vitro and In Vivo Investigation
Abstract
:1. Introduction
2. Materials and Methods
2.1. The Fungal Culture
2.2. Green Synthesis of SeNPs
2.3. Characterization of SeNPs
2.4. Antibacterial Efficacy of SeNPs against Staphylococcus aureus In Vitro
2.4.1. Minimum Inhibitory Concentration (MIC) Estimation
2.4.2. Scanning Electron Microscopy (SEM) of SeNP-Treated and Untreated S. aureus Cells Morphology
2.5. Mouse Model of Wound Infection
2.5.1. Acquisition of Animals
2.5.2. Excision Wound Development
2.5.3. Groups and Treatment
2.6. Macroscopic Estimation of Wound Size
2.7. Bacterial Load Determination
2.8. Histopathological Studies
2.9. Detection of Inflammatory Mediators
2.10. In-Silico Docking Interaction Study
2.11. Statistical Analysis
3. Results
3.1. SeNPs Myco-fabrication and Characterization
3.2. Antibacterial Activity of SeNPs
3.2.1. Minimum Inhibitory Concentration (MIC)
3.2.2. Bacterial Morphology Examination by SEM
3.3. In Vivo Experimental Study
3.3.1. Bacterial Load Determination
3.3.2. SeNPs Effects on Wound Diameter
3.3.3. Histological Studies
3.3.4. Proinflammatory Cytokines Detection
3.4. Docking Study
4. Discussion
5. Conclusions
Author Contributions
Funding
Institutional Review Board Statement
Informed Consent Statement
Data Availability Statement
Acknowledgments
Conflicts of Interest
References
- Jiang, L.; Loo, S.C.J. Intelligent Nanoparticle-Based Dressings for Bacterial Wound Infections. ACS Appl. Bio Mater. 2021, 4, 3849–3862. [Google Scholar] [CrossRef] [PubMed]
- Hamblin, M.R. Novel Pharmacotherapy for Burn Wounds: What Are the Advancements. Expert Opin. Pharmacother. 2019, 20, 305–321. [Google Scholar] [CrossRef] [PubMed]
- Cefalu, J.E.; Barrier, K.M.; Davis, A.H. Wound Infections in Critical Care. Crit. Care Nurs. Clin. N. Am. 2017, 29, 81–96. [Google Scholar] [CrossRef]
- Qiu, L.; Wang, C.; Lei, X.; Du, X.; Guo, Q.; Zhou, S.; Cui, P.; Hong, T.; Jiang, P.; Wang, J.; et al. Gelatinase-Responsive Release of an Antibacterial Photodynamic Peptide against: Staphylococcus Aureus. Biomater. Sci. 2021, 9, 3433–3444. [Google Scholar] [CrossRef] [PubMed]
- Kanji, S.; Das, H. Advances of Stem Cell Therapeutics in Cutaneous Wound Healing and Regeneration. Mediat. Inflamm. 2017, 2017, 1–14. [Google Scholar] [CrossRef] [PubMed]
- Kaushik, M.; Niranjan, R.; Thangam, R.; Madhan, B.; Pandiyarasan, V.; Ramachandran, C.; Oh, D.-H.; Venkatasubbu, G.D. Investigations on the Antimicrobial Activity and Wound Healing Potential of ZnO Nanoparticles. Appl. Surf. Sci. 2019, 479, 1169–1177. [Google Scholar] [CrossRef]
- Attallah, N.G.M.; Elekhnawy, E.; Negm, W.A.; Hussein, I.A.; Mokhtar, F.A.; Al-Fakhrany, O.M. In Vivo and In Vitro Antimicrobial Activity of Biogenic Silver Nanoparticles against Staphylococcus Aureus Clinical Isolates. Pharmaceuticals 2022, 15, 194. [Google Scholar] [CrossRef]
- Pang, Q.; Jiang, Z.; Wu, K.; Hou, R.; Zhu, Y. Nanomaterials-Based Wound Dressing for Advanced Management of Infected Wound. Antibiotics 2023, 12, 351. [Google Scholar] [CrossRef]
- He, J.; Qiao, Y.; Zhang, H.; Zhao, J.; Li, W.; Xie, T.; Zhong, D.; Wei, Q.; Hua, S.; Yu, Y.; et al. Gold–Silver Nanoshells Promote Wound Healing from Drug-Resistant Bacteria Infection and Enable Monitoring via Surface-Enhanced Raman Scattering Imaging. Biomaterials 2020, 234, 119763. [Google Scholar] [CrossRef]
- Xu, C.; Akakuru, O.U.; Ma, X.; Zheng, J.; Zheng, J.; Wu, A. Nanoparticle-Based Wound Dressing: Recent Progress in the Detection and Therapy of Bacterial Infections. Bioconjug. Chem. 2020, 31, 1708–1723. [Google Scholar] [CrossRef]
- Fang, M.; Zhang, H.; Wang, Y.; Zhang, H.; Zhang, D.; Xu, P. Biomimetic Selenium Nanosystems for Infectious Wound Healing. Eng. Regen. 2023, 4, 152–160. [Google Scholar] [CrossRef]
- Chen, C.; Wang, Y.; Zhang, D.; Wu, X.; Zhao, Y.; Shang, L.; Ren, J.; Zhao, Y. Natural Polysaccharide Based Complex Drug Delivery System from Microfluidic Electrospray for Wound Healing. Appl. Mater. Today 2021, 23, 101000. [Google Scholar] [CrossRef]
- Keshta, A.T.; Emam, M.; Attia, Y.A. Effect of Selenium Nanoparticles in Wound Healing. Biochem. Lett. 2020, 16, 160–168. [Google Scholar]
- Cheng, L.; Cai, Z.; Ye, T.; Yu, X.; Chen, Z.; Yan, Y.; Qi, J.; Wang, L.; Liu, Z.; Cui, W.; et al. Injectable Polypeptide-Protein Hydrogels for Promoting Infected Wound Healing. Adv. Funct. Mater. 2020, 30, 2001196. [Google Scholar] [CrossRef]
- Luo, L.; Wang, Y.; Zhang, S.; Guo, L.; Jia, G.; Lin, W.; Gao, Z.; Gao, Y.; Sun, T. Preparation and Characterization of Selenium-Rich Polysaccharide from Phellinus Igniarius and Its Effects on Wound Healing. Carbohydr. Polym. 2021, 264, 117982. [Google Scholar] [CrossRef]
- Tian, J.; Wei, X.; Zhang, W.; Xu, A. Effects of Selenium Nanoparticles Combined With Radiotherapy on Lung Cancer Cells. Front. Bioeng. Biotechnol. 2020, 8, 598997. [Google Scholar] [CrossRef] [PubMed]
- Zhang, H.; Zhang, Z.; Zhang, H.; Chen, C.; Zhang, D.; Zhao, Y. Protein-Based Hybrid Responsive Microparticles for Wound Healing. ACS Appl. Mater. Interfaces 2021, 13, 18413–18422. [Google Scholar] [CrossRef] [PubMed]
- Zhang, H.; Xu, D.; Zhang, Y.; Li, M.; Chai, R. Silk Fibroin Hydrogels for Biomedical Applications. Smart Med. 2022, 1, e20220011. [Google Scholar] [CrossRef]
- Salem, S.S. Bio-Fabrication of Selenium Nanoparticles Using Baker’s Yeast Extract and Its Antimicrobial Efficacy on Food Borne Pathogens. Appl. Biochem. Biotechnol. 2022, 194, 1898–1910. [Google Scholar] [CrossRef]
- Serov, D.A.; Khabatova, V.V.; Vodeneev, V.; Li, R.; Gudkov, S. V A Review of the Antibacterial, Fungicidal and Antiviral Properties of Selenium Nanoparticles. Materials 2023, 16, 5363. [Google Scholar] [CrossRef]
- Morad, M.Y.; El-Sayed, H.; Elhenawy, A.A.; Korany, S.M.; Aloufi, A.S.; Ibrahim, A.M. Myco-Synthesized Molluscicidal and Larvicidal Selenium Nanoparticles: A New Strategy to Control Biomphalaria Alexandrina Snails and Larvae of Schistosoma Mansoni with an In Silico Study on Induced Oxidative Stress. J. Fungi 2022, 8, 262. [Google Scholar] [CrossRef] [PubMed]
- Hussein, H.G.; El-Sayed, E.-S.R.; Younis, N.A.; Hamdy, A.E.H.A.; Easa, S.M. Harnessing Endophytic Fungi for Biosynthesis of Selenium Nanoparticles and Exploring Their Bioactivities. AMB Express 2022, 12, 68. [Google Scholar] [CrossRef] [PubMed]
- Balouiri, M.; Sadiki, M.; Ibnsouda, S.K. Methods for in Vitro Evaluating Antimicrobial Activity: A Review. J. Pharm. Anal. 2016, 6, 71–79. [Google Scholar] [CrossRef] [PubMed]
- CLSI. M100 Performance Standards for Antimicrobial Susceptibility Testing, 31st ed.; Clinical and Laboratory Standards Institute: Pittsburgh, PA, USA, 2021; ISBN 9781684401048. [Google Scholar]
- Lemos, M.L.; Toranzo, A.E.; Barja, J.L. Antibiotic Activity of Epiphytic Bacteria Isolated from Intertidal Seaweeds. Microb. Ecol. 1985, 11, 149–163. [Google Scholar] [CrossRef] [PubMed]
- Shamseldean, M.; Platzer, E. Romanomermis Culicivorax: Penetration of Larval Mosquitoes. J. Invertebr. Pathol. 1989, 54, 191–199. [Google Scholar] [CrossRef] [PubMed]
- Haidari, H.; Bright, R.; Strudwick, X.L.; Garg, S.; Vasilev, K.; Cowin, A.J.; Kopecki, Z. Multifunctional Ultrasmall AgNP Hydrogel Accelerates Healing of S. Aureus Infected Wounds. Acta Biomater. 2021, 128, 420–434. [Google Scholar] [CrossRef] [PubMed]
- Standage, S.W.; Caldwell, C.C.; Zingarelli, B.; Wong, H.R. Reduced Peroxisome Proliferator-Activated Receptor α Expression Is Associated with Decreased Survival and Increased Tissue Bacterial Load in Sepsis. Shock 2012, 37, 164–169. [Google Scholar] [CrossRef]
- Khalaf, A.A.; Hassanen, E.I.; Zaki, A.R.; Tohamy, A.F.; Ibrahim, M.A. Histopathological, Immunohistochemical, and Molecular Studies for Determination of Wound Age and Vitality in Rats. Int. Wound J. 2019, 16, 1416–1425. [Google Scholar] [CrossRef]
- Van De Vyver, M.; Boodhoo, K.; Frazier, T.; Hamel, K.; Kopcewicz, M.; Levi, B.; Maartens, M.; Machcinska, S.; Nunez, J.; Pagani, C.; et al. Histology Scoring System for Murine Cutaneous Wounds. Stem Cells Dev. 2021, 30, 1141–1152. [Google Scholar] [CrossRef]
- Somers, W.; Stahl, M.; Seehra, J.S. 1.9 Å Crystal Structure of Interleukin 6: Implications for a Novel Mode of Receptor Dimerization and Signaling. EMBO J. 1997, 16, 989–997. [Google Scholar] [CrossRef]
- He, M.M.; Smith, A.S.; Oslob, J.D.; Flanagan, W.M.; Braisted, A.C.; Whitty, A.; Cancilla, M.T.; Wang, J.; Lugovskoy, A.A.; Yoburn, J.C.; et al. Small-Molecule Inhibition of TNF-α. Science 2005, 310, 1022–1025. [Google Scholar] [CrossRef]
- Simonetti, O.; Rizzetto, G.; Radi, G.; Molinelli, E.; Cirioni, O.; Giacometti, A.; Offidani, A. New Perspectives on Old and New Therapies of Staphylococcal Skin Infections: The Role of Biofilm Targeting in Wound Healing. Antibiotics 2021, 10, 1377. [Google Scholar] [CrossRef] [PubMed]
- Norris, G.R.; Checketts, J.X.; Scott, J.T.; Vassar, M.; Norris, B.L.; Giannoudis, P.V. Prevalence of Deep Surgical Site Infection after Repair of Periarticular Knee Fractures: A Systematic Review and Meta-Analysis. JAMA Netw. Open 2019, 2, e199951. [Google Scholar] [CrossRef] [PubMed]
- Liu, W.; Gao, R.; Yang, C.; Feng, Z.; Ou-Yang, W.; Pan, X.; Huang, P.; Zhang, C.; Kong, D.; Wang, W. ECM-Mimetic Immunomodulatory Hydrogel for Methicillin-Resistant Staphylococcus aureus-Infected Chronic Skin Wound Healing. Sci. Adv. 2022, 8, eabn7006. [Google Scholar] [CrossRef] [PubMed]
- Golmohammadi, R.; Najar-Peerayeh, S.; Tohidi Moghadam, T.; Hosseini, S.M.J. Synergistic Antibacterial Activity and Wound Healing Properties of Selenium-Chitosan-Mupirocin Nanohybrid System: An in Vivo Study on Rat Diabetic Staphylococcus Aureus Wound Infection Model. Sci. Rep. 2020, 10, 2854. [Google Scholar] [CrossRef] [PubMed]
- Fouda, A.; Abdel-Maksoud, G.; Abdel-Rahman, M.A.; Salem, S.S.; Hassan, S.E.-D.; El-Sadany, M.A.-H. Eco-Friendly Approach Utilizing Green Synthesized Nanoparticles for Paper Conservation against Microbes Involved in Biodeterioration of Archaeological Manuscript. Int. Biodeterior. Biodegrad. 2019, 142, 160–169. [Google Scholar] [CrossRef]
- Joshi, S.M.; De Britto, S.; Jogaiah, S.; Ito, S.I. Mycogenic Selenium Nanoparticles as Potential New Generation Broad Spectrum Antifungal Molecules. Biomolecules 2019, 9, 419. [Google Scholar] [CrossRef]
- Amin, B.H.; Ahmed, H.Y.; El Gazzar, E.M.; Badawy, M.M.M. Enhancement the Mycosynthesis of Selenium Nanoparticles by Using Gamma Radiation. Dose. Response 2021, 19, 15593258211059324. [Google Scholar] [CrossRef]
- Vahidi, H.; Kobarfard, F.; Kosar, Z.; Mahjoub, M.A.; Saravanan, M.; Barabadi, H. Mycosynthesis and Characterization of Selenium Nanoparticles Using Standard Penicillium Chrysogenum PTCC 5031 and Their Antibacterial Activity: A Novel Approach in Microbial Nanotechnology. Nanomed. J. 2020, 7, 315–323. [Google Scholar] [CrossRef]
- El-Saadony, M.T.; Saad, A.M.; Taha, T.F.; Najjar, A.A.; Zabermawi, N.M.; Nader, M.M.; AbuQamar, S.F.; El-Tarabily, K.A.; Salama, A. Selenium Nanoparticles from Lactobacillus Paracasei HM1 Capable of Antagonizing Animal Pathogenic Fungi as a New Source from Human Breast Milk. Saudi J. Biol. Sci. 2021, 28, 6782–6794. [Google Scholar] [CrossRef]
- Shrestha, S.; Wang, B.; Dutta, P. Nanoparticle Processing: Understanding and Controlling Aggregation. Adv. Colloid Interface Sci. 2020, 279, 102162. [Google Scholar] [CrossRef]
- Piacenza, E.; Presentato, A.; Ferrante, F.; Cavallaro, G.; Alduina, R.; Chillura Martino, D.F. Biogenic Selenium Nanoparticles: A Fine Characterization to Unveil Their Thermodynamic Stability. Nanomaterials 2021, 11, 1195. [Google Scholar] [CrossRef] [PubMed]
- Barabadi, H.; Kobarfard, F.; Vahidi, H. Biosynthesis and Characterization of Biogenic Tellurium Nanoparticles by Using Penicillium Chrysogenum PTCC 5031: A Novel Approach in Gold Biotechnology. Iran. J. Pharm. Res. 2018, 17, 87–97. [Google Scholar] [PubMed]
- Rajkumar, K.; Sandhya, M.V.S.; Koganti, S.; Burgula, S. Selenium Nanoparticles Synthesized Using Pseudomonas Stutzeri (Mh191156) Show Antiproliferative and Anti-Angiogenic Activity against Cervical Cancer Cells. Int. J. Nanomed. 2020, 15, 4523–4540. [Google Scholar] [CrossRef]
- Al-Brakati, A.; Alsharif, K.F.; Alzahrani, K.J.; Kabrah, S.; Al-Amer, O.; Oyouni, A.A.; Habotta, O.A.; Lokman, M.S.; Bauomy, A.A.; Kassab, R.B.; et al. Using Green Biosynthesized Lycopene-Coated Selenium Nanoparticles to Rescue Renal Damage in Glycerol-Induced Acute Kidney Injury in Rats. Int. J. Nanomed. 2021, 16, 4335–4349. [Google Scholar] [CrossRef] [PubMed]
- Alagesan, V.; Venugopal, S. Green Synthesis of Selenium Nanoparticle Using Leaves Extract of Withania Somnifera and Its Biological Applications and Photocatalytic Activities. Bionanoscience 2019, 9, 105–116. [Google Scholar] [CrossRef]
- Amin, M.A.; Ismail, M.A.; Badawy, A.A.; Awad, M.A.; Hamza, M.F.; Awad, M.F.; Fouda, A. The Potency of Fungal-Fabricated Selenium Nanoparticles to Improve the Growth Performance of Helianthus annuus L. and Control of Cutworm Agrotis ipsilon. Catalysts 2021, 11, 1551. [Google Scholar] [CrossRef]
- Lian, S.; Diko, C.S.; Yan, Y.; Li, Z.; Zhang, H.; Ma, Q.; Qu, Y. Characterization of Biogenic Selenium Nanoparticles Derived from Cell-Free Extracts of a Novel Yeast Magnusiomyces Ingens. 3 Biotech 2019, 9, 221. [Google Scholar] [CrossRef]
- Salem, S.S.; Fouda, M.M.G.; Fouda, A.; Awad, M.A.; Al-Olayan, E.M.; Allam, A.A.; Shaheen, T.I. Antibacterial, Cytotoxicity and Larvicidal Activity of Green Synthesized Selenium Nanoparticles Using Penicillium Corylophilum. J. Clust. Sci. 2021, 32, 351–361. [Google Scholar] [CrossRef]
- Vahdati, M.; Moghadam, T.T. Synthesis and Characterization of Selenium Nanoparticles-Lysozyme Nanohybrid System with Synergistic Antibacterial Properties. Sci. Rep. 2020, 10, 510. [Google Scholar] [CrossRef] [PubMed]
- Eleraky, N.E.; Allam, A.; Hassan, S.B.; Omar, M.M. Nanomedicine Fight against Antibacterial Resistance: An Overview of the Recent Pharmaceutical Innovations. Pharmaceutics 2020, 12, 142. [Google Scholar] [CrossRef] [PubMed]
- Filipović, N.; Ušjak, D.; Milenković, M.T.; Zheng, K.; Liverani, L.; Boccaccini, A.R.; Stevanović, M.M. Comparative Study of the Antimicrobial Activity of Selenium Nanoparticles With Different Surface Chemistry and Structure. Front. Bioeng. Biotechnol. 2021, 8, 624621. [Google Scholar] [CrossRef] [PubMed]
- Wang, L.; Hu, C.; Shao, L. The Antimicrobial Activity of Nanoparticles: Present Situation and Prospects for the Future. Int. J. Nanomed. 2017, 12, 1227–1249. [Google Scholar] [CrossRef]
- Elsaied, B.E.F.; Diab, A.M.; Tayel, A.A.; Alghuthaymi, M.A.; Moussa, S.H. Potent Antibacterial Action of Phycosynthesized Selenium Nanoparticles Using Spirulina Platensis Extract. Green Process. Synth. 2021, 10, 49–60. [Google Scholar] [CrossRef]
- Deyhimi, P.; Khademi, H.; Birang, R.; Akhoondzadeh, M. Histological Evaluation of Wound Healing Process after Photodynamic Therapy of Rat Oral Mucosal Ulcer. J. Dent. 2016, 17, 43. [Google Scholar]
- Gupta, A.; Kumar, P. Assessment of the Histological State of the Healing Wound. Plast. Aesthetic Res. 2015, 2, 239–242. [Google Scholar] [CrossRef]
- Santos, T.S.; Dos Santos, I.D.D.; Pereira-Filho, R.N.; Gomes, S.V.F.; Lima-Verde, I.B.; Marques, M.N.; Cardoso, J.C.; Severino, P.; Souto, E.B.; de Albuquerque-Júnior, R.L.C. Histological Evidence of Wound Healing Improvement in Rats Treated with Oral Administration of Hydroalcoholic Extract of Vitis Labrusca. Curr. Issues Mol. Biol. 2021, 43, 335–352. [Google Scholar] [CrossRef]
- Kamel, R.; El-batanony, R.; Salama, A. Pioglitazone-Loaded Three-Dimensional Composite Polymeric Scaffolds: A Proof of Concept Study in Wounded Diabetic Rats. Int. J. Pharm. 2019, 570, 118667. [Google Scholar] [CrossRef]
- MacLeod, A.S.; Kwock, J.T. Inflammation in Wound Repair: Role and Function of Inflammation in Wound Repair. In Wound Healing; John Wiley & Sons, Ltd.: Hoboken, NJ, USA, 2018; pp. 177–194. ISBN 9781119282518. [Google Scholar]
- Wagner, W.; Pascolo, S.; Zenner, H.-P. Differential Cytokine Activity during Wound Healing in the Neonatal and Adult Rat Skin. Otolaryngol.-Head Neck Surg. 2005, 133, P36. [Google Scholar] [CrossRef]
- Gabay, C. Interleukin-6 and Chronic Inflammation. Arthritis Res. Ther. 2006, 8, S3. [Google Scholar] [CrossRef]
- Nguyen, V.-L.; Truong, C.-T.; Nguyen, B.; Vo, V.T.N.; Dao, T.-T.; Nguyen, D.; Trinh, D.-T.; Huynh, H.; Bui, C.-B. Anti-Inflammatory and Wound Healing Activities of Calophyllolide Isolated from Calophyllum Inophyllum Linn. PLoS ONE 2017, 12, e0185674. [Google Scholar] [CrossRef] [PubMed]
- Pereira, F.; Gushiken, L.; Vieira, A.; Bérgamo, D.; Bérgamo, P.; Souza, M.; Hussni, C.; Takahira, R.; Nóbrega, R.; Martinez, E.; et al. From Inflammation to Cutaneous Repair: Topical Application of Lupeol Improves Skin Wound Healing in Rats by Modulating the Cytokine Levels, NF-ΚB, Ki-67, Growth Factor Expression, and Distribution of Collagen Fibers. Int. J. Mol. Sci. 2020, 21, 4952. [Google Scholar] [CrossRef] [PubMed]
- Ashcroft, G.S.; Jeong, M.-J.; Ashworth, J.J.; Hardman, M.; Jin, W.; Moutsopoulos, N.; Wild, T.; McCartney-Francis, N.; Sim, D.; McGrady, G.; et al. Tumor Necrosis Factor-Alpha (TNF-α) Is a Therapeutic Target for Impaired Cutaneous Wound Healing. Wound Repair Regen. 2012, 20, 38–49. [Google Scholar] [CrossRef]
- Martinez, F.; Helming, L.; Gordon, S. Alternative Activation of Macrophages: An Immunologic Functional Perspective. Annu. Rev. Immunol. 2009, 27, 451–483. [Google Scholar] [CrossRef] [PubMed]
- Hedayatyanfard, K.; Haddadi, N.-S.; Ziai, S.A.; Karim, H.; Niazi, F.; Steckelings, U.M.; Habibi, B.; Modarressi, A.; Dehpour, A.-R. The Renin-Angiotensin System in Cutaneous Hypertrophic Scar and Keloid Formation. Exp. Dermatol. 2020, 29, 902–909. [Google Scholar] [CrossRef]
- Kawarazaki, A.; Horinaka, M.; Yasuda, S.; Numajiri, T.; Nishino, K.; Sakai, T. Sulforaphane Suppresses Cell Growth and Collagen Expression of Keloid Fibroblasts. Wound Repair Regen. 2017, 25, 224–233. [Google Scholar] [CrossRef]
- Elenkov, I.; Chrousos, G. Stress Hormones, Proinflammatory and Antiinflammatory Cytokines, and Autoimmunity. Ann. N. Y. Acad. Sci. 2002, 966, 290–303. [Google Scholar] [CrossRef]
- Lowenstein, C.; Hill, S.; Lafond-Walker, A.; Wu, J.; Allen, G.; Landavere, M.; Rose, N.; Herskowitz, A. Nitric Oxide Inhibits Viral Replication in Murine Myocarditis. J. Clin. Investig. 1996, 97, 1837–1843. [Google Scholar] [CrossRef]
- Salman, H.; Yaakop, A.; Aladaileh, S.; Mustafa, M.; Gharaibeh, M.; Kahar, U. Inhibitory Effects of Ephedra Alte on IL-6, Hybrid TLR4, TNF-α, IL-1β, and Extracted TLR4 Receptors: In Silico Molecular Docking. Heliyon 2022, 9, e12730. [Google Scholar] [CrossRef] [PubMed]
- Nosenko, M.; Ambaryan, S.; Drutskaya, M. Proinflammatory Cytokines and Skin Wound Healing in Mice. Mol. Biol. 2019, 53, 653–664. [Google Scholar] [CrossRef]

is significantly diferent by one-way ANOVA (p < 0.05) compared with negative control.
is significantly diferent by one-way ANOVA (p < 0.05) compared with negative control.

| PDB ID | Docking Score (Kcal/mol) | Interaction Type | Amino Acid Residue |
|---|---|---|---|
| IL-6 (1alu) | −2.2 | H-acceptor | ARG 104 |
| TNF-α (2az5) | −1.7 −0.4 | H-donor H-donor | PRO 139 LEU 142 |
Disclaimer/Publisher’s Note: The statements, opinions and data contained in all publications are solely those of the individual author(s) and contributor(s) and not of MDPI and/or the editor(s). MDPI and/or the editor(s) disclaim responsibility for any injury to people or property resulting from any ideas, methods, instructions or products referred to in the content. |
© 2023 by the authors. Licensee MDPI, Basel, Switzerland. This article is an open access article distributed under the terms and conditions of the Creative Commons Attribution (CC BY) license (https://creativecommons.org/licenses/by/4.0/).
Share and Cite
El-Sayed, H.; Morad, M.Y.; Sonbol, H.; Hammam, O.A.; Abd El-Hameed, R.M.; Ellethy, R.A.; Ibrahim, A.M.; Hamada, M.A. Myco-Synthesized Selenium Nanoparticles as Wound Healing and Antibacterial Agent: An In Vitro and In Vivo Investigation. Microorganisms 2023, 11, 2341. https://doi.org/10.3390/microorganisms11092341
El-Sayed H, Morad MY, Sonbol H, Hammam OA, Abd El-Hameed RM, Ellethy RA, Ibrahim AM, Hamada MA. Myco-Synthesized Selenium Nanoparticles as Wound Healing and Antibacterial Agent: An In Vitro and In Vivo Investigation. Microorganisms. 2023; 11(9):2341. https://doi.org/10.3390/microorganisms11092341
Chicago/Turabian StyleEl-Sayed, Heba, Mostafa Y. Morad, Hana Sonbol, Olfat A. Hammam, Rehab M. Abd El-Hameed, Rania A. Ellethy, Amina M. Ibrahim, and Marwa A. Hamada. 2023. "Myco-Synthesized Selenium Nanoparticles as Wound Healing and Antibacterial Agent: An In Vitro and In Vivo Investigation" Microorganisms 11, no. 9: 2341. https://doi.org/10.3390/microorganisms11092341
APA StyleEl-Sayed, H., Morad, M. Y., Sonbol, H., Hammam, O. A., Abd El-Hameed, R. M., Ellethy, R. A., Ibrahim, A. M., & Hamada, M. A. (2023). Myco-Synthesized Selenium Nanoparticles as Wound Healing and Antibacterial Agent: An In Vitro and In Vivo Investigation. Microorganisms, 11(9), 2341. https://doi.org/10.3390/microorganisms11092341

